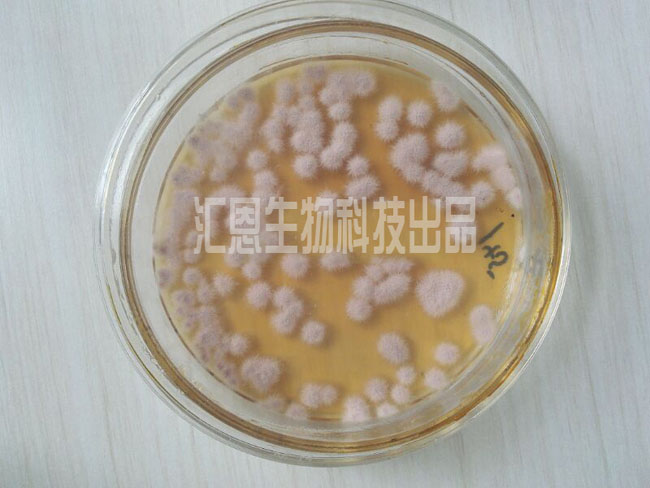

淡紫拟青霉是土壤中多种植物根系的习居菌(土壤习居菌是指在土壤内或病株残体上越冬,腐生性较强,能在土壤中长期存活的寄生菌),是目前人们研究应用广泛的线虫卵寄生真菌,能够有效防治根结线虫和胞囊线虫,对南方根结线虫的卵寄生率高达60%~70%。

番茄根结线虫▲
自1979年首次从南方根结线虫卵中分离出来,国内外许多学者对淡紫拟青霉开始了长达30多年的应用研究。
Davide等用淡紫拟青霉浸薯块或直接将菌剂施入土中防治马铃薯金线虫,施用菌剂后马铃薯增产20.3%~36.5%;防治秋葵根结线虫,施菌3个月后,线虫比对照减少66%~77%,荚数增加39%~41%,重量增加45%~54%;Latha等的试验表明,淡紫拟青霉的滤液可以减少黑鹰嘴豆上木豆异皮线虫胞囊和幼虫的数量。
菲律宾亚州技术中心则是将淡紫拟青霉商品化,在秘鲁、美国、巴基斯坦等地用于防治马铃薯线虫,效果显着。

柑橘根结线虫▲
多年实践证明,淡紫拟青霉对多种线虫都有防治效果,其寄主有根结线虫、胞囊线虫、肾形线虫、穿刺(半穿刺)线虫、金色线虫、异皮线虫,是防治线虫的生防制剂。由于该菌可适应不同的气候条件,对线虫卵具有较高的寄生率,可以有效控制土壤线虫数量,明显减少危害,已被广泛用于生产实践中。目前,世界近70个国家的线虫学家用它来防治根结线虫、胞囊线虫等植物寄生线虫,并取得了较好的效果。
作为生防菌,淡紫拟青霉对营养条件要求不高,它不仅能在多种常规培养基上生长,并能在多种自然基质如农副产品废料、废渣与植物叶片或植物浸提液中生长,而且可以产生大量孢子,这就便于对其进行大规模工业化发酵生产,可以制成固体或液体菌剂,用于根施、拌种或喷施。因此,近年来国内外相继开展了利用淡紫拟青霉菌对寄生线虫进行生物防治的应用研究,我国也采用液体、固体发酵技术工业化生产商品制剂,在黑龙江、云南、江苏等地防治大豆孢囊线虫和南方根结线虫效果显着,并筛选淡紫拟青霉菌优良菌株进行开发利用,生产商品制剂。但是由于自然筛选的菌株寄生率不高,剂型开发效果不好,生防机制等还不清楚,菌剂的防治效果偏低,限制了该菌的开发利用。

根结线虫雌虫▲
此外,随着淡紫拟青霉研究的不断深入,其次生代谢物生理功效的研究也成为热点。淡紫拟青霉能够产生多种功能酶如脱乙酰几丁质酶、细胞裂解酶、葡聚糖酶与丝氨酸蛋白酶等,尤其脱乙酰几丁质酶是一种新近发现的酶,对其催化特性和分子结构尚有许多值得探索的问题,特别是应用脱乙酰几丁质酶防治植物的病原菌方面将有非常广阔的前景,而国内开展这方面的研究较少,需要加强其研究和开发。
目前,我国应用多的有机农药尤其是有机磷农药已经成为严重的环境污染物,淡紫拟青霉在作为一种有效生防菌的同时还可以进一步研究成为一种治理农药及污水处理的有效微生物,这也将成为微生物治理环境污染的热点。随着研究的不断深入,淡紫拟青霉在发酵工艺、剂型开发、菌剂保存等方面将会有更大的突破,必将在生物防治上起到更重要的作用。同时,随着分子生物学等学科间的相互渗透与协作,在功能基因研究、基因调控、致病机理、基因重组等基础研究上亦将有着更大的发展前景。
然而,生物活性制剂的使用效果受到很多环境因素的影响,温度、水分、pH值都影响淡紫拟青霉在环境中的存活及繁殖。

生防战线对线虫的防治效果对比图
鹤壁市汇恩生物科技有限公司研制的淡紫拟青霉,不仅有效活菌数高达5.0亿/g以上,而且抵抗外界不良因素的能力提高,产品性能更加稳定,生物活性更强。淡紫拟青霉在繁殖过程中还可产生类似吲哚乙酸的物质,能够促进根系生长。在根治线虫上更是具有高效、长效、安全、无污染、无残留等特点。不仅能抑制线虫侵染,而且能促进植物根系及植株营养器官的生长,可实现苗全、苗绿、苗壮,一般可使作物增产10%以上。
功能特点:
1、高效、持效期长:该产品通过食线虫菌的大量萌发、繁殖,达到杀死线虫及虫卵的目的,持效期长,一季作物只需使用一次即可达到防治效果,并对地老虎、蛴螬、蝼蛄等地下害虫有较强的趋避作用;
2、产生的代谢产物具有提高农作物产品产量、质量的作用;
3、环保性:产品施用后无残留,对环境无污染;
4、无抗性:产品克服了化学杀虫剂不断使用后导致害虫产生抗性的缺陷;
5、安全性:该产品是纯生物制剂,对作物不会产生药害,对人畜安全。
防治对象:大田、蔬菜、果树、花卉、烟草等农作物。
使用方法:
1、有机肥添加剂:一吨有机肥添加2-3公斤与有机肥混合使用。
2、拌种:按种子量的1%进行拌种后,堆捂2-3小时、阴干即可播种。
3、育苗基质:将1公斤菌剂均匀拌入1-1.5方基质中,装入育苗容器中。
4、穴施:施在种子或种苗根系附近,亩用量1-2公斤。
注意事项:
1、勿与杀菌剂混合施用。
2、施药时间为早上或傍晚。勿使药剂直接放置于强阳光下。
3、贮存于阴凉干燥处,勿使产品受潮,影响产品使用效果。
如果您想了解更多关于“别再纠结根结线虫怎么办了,快看这里”相关内容资讯。
欢迎拨打我们的免费热线:17752599117,或点击在线咨询汇恩生物公司客服。